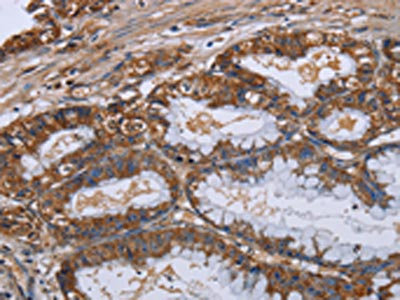

LUM Antibody
-
中文名稱:LUM兔多克隆抗體
-
貨號:CSB-PA788951
-
規格:¥1100
-
圖片:
-
The image on the left is immunohistochemistry of paraffin-embedded Human brain tissue using CSB-PA788951(LUM Antibody) at dilution 1/20, on the right is treated with fusion protein. (Original magnification: ×200)
-
The image on the left is immunohistochemistry of paraffin-embedded Human esophagus cancer tissue using CSB-PA788951(LUM Antibody) at dilution 1/20, on the right is treated with fusion protein. (Original magnification: ×200)
-
-
其他:
產品詳情
-
Uniprot No.:
-
基因名:LUM
-
別名:Keratan sulfate proteoglycan lumican antibody; KSPG lumican antibody; LDC antibody; LUM antibody; LUM_HUMAN antibody; Lumican antibody; Lumican precursor antibody; SLRR2D antibody
-
宿主:Rabbit
-
反應種屬:Human,Mouse,Rat
-
免疫原:Fusion protein of Human LUM
-
免疫原種屬:Homo sapiens (Human)
-
標記方式:Non-conjugated
-
抗體亞型:IgG
-
純化方式:Antigen affinity purification
-
濃度:It differs from different batches. Please contact us to confirm it.
-
保存緩沖液:-20°C, pH7.4 PBS, 0.05% NaN3, 40% Glycerol
-
產品提供形式:Liquid
-
應用范圍:ELISA,IHC
-
推薦稀釋比:
Application Recommended Dilution ELISA 1:1000-1:2000 IHC 1:25-1:100 -
Protocols:
-
儲存條件:Upon receipt, store at -20°C or -80°C. Avoid repeated freeze.
-
貨期:Basically, we can dispatch the products out in 1-3 working days after receiving your orders. Delivery time maybe differs from different purchasing way or location, please kindly consult your local distributors for specific delivery time.
-
用途:For Research Use Only. Not for use in diagnostic or therapeutic procedures.
相關產品
靶點詳情
-
基因功能參考文獻:
- Our data suggests that the endometrium of patients with polycystic ovary syndrome (PCOS) exhibits higher expressions of decorin and lumican than that of healthy control women in the proliferative phase of the menstrual cycle. It is then possible that this proteoglycan excess may interfere with normal endometrial hemostasis in PCOS. PMID: 28789706
- Cancer-associated fibroblast-derived Lumican contributes to tumorigenesis and metastasis of gastric cancer PMID: 28542982
- Lumican and versican protein expression are associated with colorectal adenoma-to-carcinoma progression PMID: 28481899
- Lumican is downregulated in the process of scar formation and alleviates hypertrophic scarring by suppressing integrin-FAK signaling. PMID: 27693693
- ectopic mutant lumican (L199P) may induce enlargement of axial lengths and abnormal structures and distributions of collagen fibrils in mouse sclera PMID: 27711221
- Quantitative polymerase chain reaction for messenger RNA expression from tissue specimens revealed significantly higher expression of Biglycan (p = 0.0008) and Lumican (p = 0.01) and lower expression of Decorin (p < 0.0001) in urothelial carcinoma of bladder PMID: 28459201
- analysis of decorin and lumican expression in fibroblasts correlated with palmoplantar collagen bundle size PMID: 26663310
- fibroblasts stimulated with the fibrocyte-secreted inflammatory signal tumor necrosis factor-alpha secrete the small leucine-rich proteoglycan lumican. PMID: 26351669
- This meta-analysis suggests that LUM polymorphisms are associated with the risk of high myopia. PMID: 24956166
- The results suggest that regions within LUM is associated with ACL injury susceptibility and that genetic sequence variability within genes encoding proteoglycans may potentially modulate the ligament fibril properties. PMID: 24552666
- meta-analysis, including 1,545 subjects from 5 studies, indicated that Chinese lumican rs3759223 C allele carriers had a decreased risk of high myopia in comparison to T allele carriers PMID: 24516061
- These findings suggest that lumican is a potent differential diagnostic marker that distinguishes hidroacanthoma simplex from clonal-type seborrheic keratosis. PMID: 23656908
- Lumican, decorin and dermatopontin are differentially expressed and may serve as biomarkers for metastatic and recurrent Giant cell tumor of bone PMID: 25304290
- Lumican binds ALK5 to promote epithelium wound healing PMID: 24367547
- Lack of Lumican expression is associated with recurrence in colon cancer. PMID: 22711178
- This meta-analysis has suggested that there is a lack of association of the rs3759223 polymorphism with high myopia risk. PMID: 24927138
- These findings suggest that lumican plays an important role in the pathogenesis of Bowen disease and actinic keratosis PMID: 23719483
- lumican may be involved in cell growth and invasion through the regulation of 24 proteins expressed in pancreatic ductal adenocarcinoma. PMID: 23846574
- This meta-analysis showed the evidence that SNP rs3759223 may affect individual susceptibility to high myopia in the Chinese population. PMID: 24061151
- Both lumican and decorin are involved in collagen fibrillogenesis and stability. PMID: 23747391
- Lumican gene can promote the proliferation of lung adenocarcinoma cell A549, and its mechanism may be related to increased RhoC and p-Akt protein expressions. PMID: 23643269
- The current study did not support an association between the promoter SNPs of the LUM gene with high myopia in the Korean population. PMID: 23145541
- Cardiac levels of lumican is increased in experimental and clinical heart failure. PMID: 23480731
- The reduction in keratan sulfate levels and the strong correlation between chondroitin 6-sulfate and keratan sulfate levels indi-cates suppressed cartilage turnover after arthroscopic surgery. PMID: 22441960
- lumican present in the reactive stroma surrounding prostate primary tumors plays a restrictive role on cancer progression PMID: 23399832
- LUM in combination with other known markers, such as CRP, could be evaluated as a panel of biomarkers of POAD. PMID: 22721676
- lumican expression and its presence in ECM has an impact on colon cancer cells motility and may modulate invasiveness of colon cancer. PMID: 22814255
- Our results confirm that the PAX6, Lumican, and MYOC genes were not associated with high myopia in the Han Chinese in Northeastern China. PMID: 22809227
- Lumican may be a potential acute aortic dissection (AAD)-related serum marker that may assist the diagnosis of AAD. PMID: 22228989
- Single nucleotide polymorphisms in lumican gene are associated with systemic lupus erythematosus in the Taiwan Chinese Han population. PMID: 21885486
- lumican and fibromodulin display different behaviors and that lumican may promote regeneration of the TMJ after degeneration and deformation induced by IL-1 beta. PMID: 22073367
- regulates osteosarcoma cell adhesion by modulating TGFbeta2 activity PMID: 21421073
- four polymorphisms of the LUM promoter contribute to the pathogenesis of high myopia. PMID: 20010793
- lumican may play a key role in the generation of a new collagen network by fibroblast-like cells PMID: 20819773
- Linkage and haplotype analyses identified 12q21.33 as a locus for posterior amorphous corneal dystrophy. However, no mutations were identified in the candidate genes (KERA, LUM, DCN, EPYC) within this region. PMID: 20357198
- lumican protein plays important roles in the inhibition of HEK cell attachment and growth, and it might inhibit the activation of integrin pathways PMID: 20138170
- These observations suggest that LUM gene polymorphisms contribute to the development of high myopia. PMID: 19643966
- Data suggest that five novel genes, LUM, PDE3B, PDGF-C, NRG1 and PKD2, have great potential for predicting the efficacy of cisplatin-based chemotherapy against OSCC. PMID: 19569180
- Expression and accumulation of lumican protein in uterine cervical cancer PMID: 11956587
- the lumican protein synthesized by cancer cells, fibroblasts and epithelial cells with mild reactive dysplasia found adjacent to cancer cells may affect the growth of human colorectal cancer cells. PMID: 12366811
- Lumican protein has an inhibitory effect on HEK 293 cell growth in vitro. PMID: 14720136
- Inverse regulation in the expression of endoglin and lumican. PMID: 14996436
- studies of lumican-transfected melanoma cells suggest that lumican is involved in the control melanoma growth and invasion and may be considered, like decorin, as an anti-tumor factor from the extracellular matrix PMID: 15149859
- Malignant cells can actively influence the composition of the extracellular matrix through TGFbeta1 and other soluble factors. PMID: 15336555
- No evidence that endothelial dysfunction and germline mutation of lumican and keratocan genes participate in the etiology of subepithelial corneal haze. PMID: 16760896
- An SNP (rs3759223), which is located in the promoter region of the lumican gene, may be worth further investigation to determine its association with development of high myopia. PMID: 16902402
- metastatic melanoma cell lines were found to express lumican mRNA and effectively secrete lumican in a proteoglycan form, characterized to be substituted mostly with keratan sulfate chains; lumican mRNA was not detected in normal melanocytes PMID: 17050378
- In addition, no pathogenic sequence variations were found in DCN, DSPG3, LUM, PITX2 and FOXC1, which have also been implicated in corneal and anterior segment dysgenesis. PMID: 17558846
- Lumican expression in stromal tissues plays an important role in the growth and invasion of pancreatic cancer. PMID: 17671699
- lumican expression may be positively correlated with the differentiation and negatively correlated with the progression of osteosarcoma PMID: 18093185
顯示更多
收起更多
-
亞細胞定位:Secreted, extracellular space, extracellular matrix.
-
蛋白家族:Small leucine-rich proteoglycan (SLRP) family, SLRP class II subfamily
-
組織特異性:Cornea and other tissues.
-
數據庫鏈接:
Most popular with customers
-
-
YWHAB Recombinant Monoclonal Antibody
Applications: ELISA, WB, IHC, IF, FC
Species Reactivity: Human, Mouse, Rat
-
-
-
-
-
-